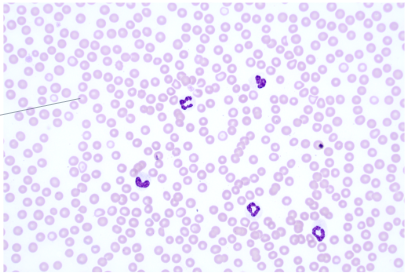
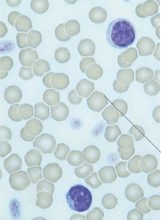
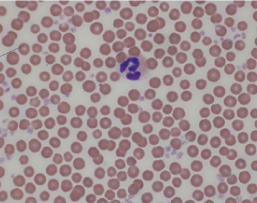
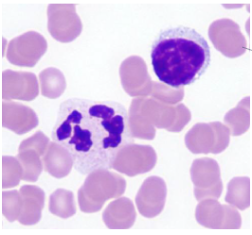
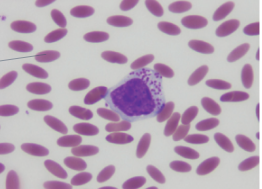

Clinical Skills 1a
1/80
There's no tags or description
Looks like no tags are added yet.
Name | Mastery | Learn | Test | Matching | Spaced |
|---|
No study sessions yet.
81 Terms
How to Pass Surgical Instruments
passed sharp end away from receiver and positioned in the surgeon’s hand ready to use
What are the three scalpel grips
pencil, fingertip, palm
How to put on scalpel blade
Grasp back side of the blade using needle holders, hold scalpel away from face and pointed down, don’t apply blade with fingers
Fingertip scapel hold is useful for
long straight incisions
Pencil scalpel blade grips is useful for
short and precise cuts
Palm scalpel grip is useful for
most power but is the least precise (tough tissue)
Press cutting is used for
stab incisions into hollow organs
Tripod grip of needle holders provides
max control, best for precise
The palm grip of needle drives is used for
application with speed and power
Hold the needle ___ of the distance from the needle tip
3/4
Introduce the needle at ____ to the incision
90 degrees
Removal of needle from tissue is optimally performed with
needle holders
Tripod grip for scissors allows for
max movement and control of scissors
Two hand tie is best for
precision but slower
One hand tie is best for
speed
Animal Component - Historical experiences
How do they do normally at the vet? What has caused concern for the animal in the past?
Animal Component - Comfort Level
illness/injury, aging and other body changes
Animal Component - Situtational Changes
New owner, changes in environment
Triage Component
what is the patient here for or what is the level of urgency for care? You need to consider both the needs of the patient and the needs of the owner
Veterinary Impact
Interpreting and understanding the behavior in your patients, quiet environment, quiet demeanor, treats, pheromones, medicines
Cattle Working Systems
Halters, squeeze chutes, head lock gates, tilt tables, ropes
Understanding Horse Language
ears, lips, nostrils, teeth/tongue movement, head and body position, tail position and movement
Equine interaction tools and techniques
halter and lead rope, hand distraction/hand twitch, mechanical twitch, stanchions/stocks, chemical support
Muzles are used to
not stop the patient from biting but to minizme damage and control the animal
What gauge needle do you generally use for large/medium animals
20g
What gauge do you generally need for smaller patients
22g
Lavender top - Additive
EDTA
Green top- Additive
Heparin
Blue top - Additive
Citrate
Red Top - Tests
Chem, serology, vit e, most endocrinology
Tiger top - Tests
can relplace red top for most chem and serologies, avoid with some endocrine/chem
Lavender top - Tests
EDTA Plasma - ACTH Endogenous/ Actch and insulin
EDTA Whole Blood - Hemogram, lead, selenium, knott’s heartworm, PCR tests
Green top - Tests
Heprinized Plasma - most chems, toxicology (cu, fe, nitrate/ite, zinc)
Heprain whole blood - Knott’s heartworm, toxiciolgy
Blue Top - Tests
Most comparative coagulation tests
Blood Culture Vials
first in order of draw,
Additives : Media to encourage growth of microbes + anticoagulant
Centrifugation: No
Blue Top
second in order of draw
Additive: Citrate
Centrifugation: Yes if you want citrate plasma
Used for: Coagulation testing
Red Top Tube
Third in order of draw
Additives : None
Centrifugation: Yes after clot has fully fromed
Used for: Chem, serologies, Vit E, Endocrine
What test can you not use red tops for
Endogenous ACTH/ACTH stimulation tests/insulin
Tiger top
third in order of draw
Additives: Serum separator
Centrifugation: Yes, after clot has fully formed
Used for: Interchangable with the red top
Green top
Fourth in order of draw
Additive: Lithium Heparin
Centriguation: Yes if you want heparinized plasms
Used for: Chem, toxicology, heartworm
Purple top
Fifth in order of draw
Additives : Postassium EDTA
Centrifugation: yes if you want plasma
Used for: CBC, insulin, endogenous ACTH, ACTH stim test, heartworm, PCRs, lead/selenium
Gray top tube
Sixth in order of draw
Additive: Sodium Fluoride (preservative) and Potassium Oxalate(Anticoagulant)
Centrifugation: Yes if you want plasma
Used for: Plasma glucose and lactic acid
Coccygeal Venipuncture
Done gloves, stand behidn teh cow and slightly to one side of the tail, hold the tail approximately a 3rd of the way from the base and with your non-dominant hand raise the tail vertically until it is horizontal to the ground, locate the groove lying in the ventral midline of the tail, midway along the body of a coccygeal vertebra, with you dominant hand insert the needle perpendicualy to the surface of the skin slwoly to a depth of a few milimetters (you may hit bone), back the need out very slowly about 1 mm and pull back on plunger, get blood and reove needle from tail, apply pressure to site for 20-30 seconds
Equine Jugular Veinpuncture
Don gloves, stand on the side of the horse you plan to use, with you non-dominant hand distend the jugular vein by compressing the proximal third of the neck (You should be able to visualize the vein now), with your dominant hand, match the angle of the vein with your syringe and needle, insert the needle completly into the vein and pull back on plunger, remove needle and apply pressure to site for 20-30 seconds
Recumency for canine jugular
seated, standing or dorsal recumbency
Recumbency of Feline Jugular
Sternal, lateral, or ventral recumbency
Canine and feline Jugular Venipuncture
Don gloves, cclude jugular with non dominant hand, with dominatn hand insert the needle into the vein at 45 angle and to a depth of a few mm, pul back, remove needle and apply pressure for 20-30 seconds
Cephalic Venipuncture
Don gloves, hold thoracic limb with non-dominant handm with dominant hand insert the needle in the vein at a 25 angle and to a depth of a few milimeters, pull back, remove needle, apply pressure for 20-30 seconds
Lateral and Medial Saphenous Veinpuncture
Don gloves, hold pelvic limb with non-dominant hand, with dominant hand insert the needle at 25 angle and to a depth of a few mm, pul back, remove needle and apply pressure for 20-30 seconds
Facial Sinus Venipuncture
Don gloves, stand on the side of the horse you plan to use, with you dominant hand insert the needle at an upwar 60 through the skin and muscle toward the base of the facial crest, the needle tip will make contact with the bone , back the needle out very slwoly 1-3 mm to enure placement of the needle and pull back, remove needle and apply presure to site for 20-30 seconds
What species blood
Dog
What species blood
feline
What species blood
Bovine
What species blood
equine
What species blood
Camelid
When to use objective x4
coat brushings and skin scrapes
When to use objective x10
parasites, urine sediment and crystals
When to use objective x40
pATHOLOGICAL SAMPLES
When to use objective x100
cytology, blood and impression smears, FNA and skin impressions
Mature bovine normal Temp
100.5-102.5
Mature bovine normal HR
40-80
mature bovine normal resp rate
10-20
Calf normal tmep
101-103
Calf nromal HR
80-120
Calf Normal Resp rate
20-40
Mature sheep normal temp
100-104
Mature sheep normal HR
70-90
Mature sheep Resp rate
20-40
lamb temp
102.5-104
Lamb hr
120-60
Lamb resp rate
20-40
Goat temp
100-104
Goat HR
70-90
Goat resp rate
20-40
Kid temp
102-104
Kid hr
120-160
Kid resp rate
20-40
Equine temp
99-101.5
Equine HR
28-42
Equine respiration
8-16